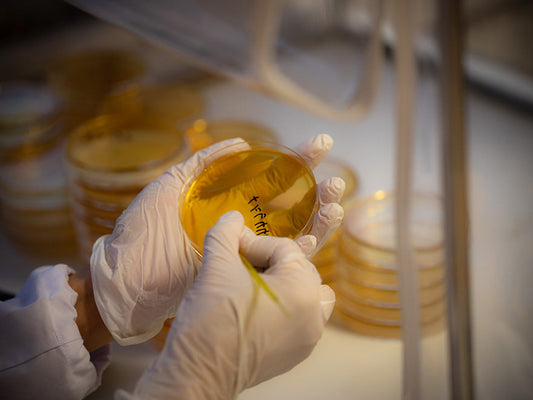
遺伝性の疾患と 腸内細菌

-

遺伝性の疾患と 腸内細菌
遺伝子解析が普及し、疾患のリスク遺伝子の保有有無がわかる時代になってきました。
それに伴い、リスク遺伝子があっても発症する場合、しない場合がある事も分かってきています。何が異なるのでしょうか? ここでは遺伝も関連する自己免疫疾患に絞って記載します。
-

腸内細菌、ムチンの住人
大腸は腸粘膜のヌメヌメで保護されています。このヌメヌメはムチンと呼ばれており、強力な腸管バリアの役割を果たしています。
-

枯渇する腸内の味方たち
Foremaでは、周辺の野生動物の腸内細菌を継続的に解析しています。そこから見えてくるのは、哺乳類には種を超えた共通性が頻繁に見られるという事です。
-

自閉症と硫化水素,デスルフォビブリオ属
次世代型シーケンサーの登場によって、過去10数年で腸内細菌の研究が飛躍的に進んでいます。その中で、腸内細菌と自閉症(以下ASD)の関係の詳細が報告されてから早10年以上が経過します。ここでは、自閉症に関連する腸内細菌の1つであるデスルフォフォビブリオ属(Desulfovibrio)について記載します。
-
自閉症と腸内細菌の話
自閉症スペクトラム障害(以下、ASD)は、社会的コミュニケーションの特性や感覚過敏、反復行動などを特徴とする神経発達特性です。
2010年以降、腸内細菌研究が飛躍的に進む中で、腸内細菌がASDに深く関わっていることがわかってきました。ここでは世にある様々な文献の他、Forema自社ラボにおける腸内細菌研究の結果も踏まえ、自閉症と腸内細菌の関係、そして将来の改善の展望も踏まえて記述します。
-

オオスズメバチの女王蜂の腸内細菌を解析する話
養蜂家さんからいただいたオオスズメバチの女王蜂の遺体から、腸内細菌の解析を進めています。
-

犬とは何が違う? 猫の腸内細菌の話
愛犬、愛猫の腸内環境を気にする飼い主さんが増えています。一方で、犬と比べて猫の腸内環境はまだ研究が進んでいません。ここでは、犬との比較という視点で、猫の腸内細菌/腸内フローラについて記述します。
-

犬の腸と皮膚,腸とメンタル
お腹の弱い個体はしばしば皮膚トラブルを併発します。お腹の弱い個体はしばしば分離不安を併発します。この時何が起きているのでしょうか?
-

犬の蛋白漏出性腸症の話
近年、愛犬が動物病院で蛋白漏出性腸症と診断される事例が増えているようです。ステロイドで対処するも、やがて効かなくなる事例も少なくありません。何が起きているのでしょうか?
-

犬と猫のジアルジア、腸内細菌、そして抗生物質
ジアルジア(原虫)の治療がきっかけで、愛犬/愛猫が長期的な不具合に至る事例があります。いったい何が起きているのでしょうか? 腸内細菌解析から見えてきた詳細を深掘りします。
-

犬の食糞はヘルプサインかもしれない
原因がわからず、また相談するのも気が引ける..。そんな背景から飼い主さんを静かに悩ませる愛犬の食糞。本当は何が起きているのでしょうか??ここでは、動物病院では教えてくれない、食糞と腸内細菌の関係についてお届けします。
-

犬と猫と抗生物質について
犬や猫の腸内細菌解析で見えてきたこと、それは抗生物質の使用が過剰になっているかもしれない、という事です。
-

下痢の原因にも??犬と猫の「芽胞菌(がほうきん)」豆知識
動物病院の便検査で「芽胞菌(がほうきん)がいますね..」と言われた事がある飼い主さんもいらっしゃるはず。時々耳にする芽胞菌とは一体なんなのか? ここでは芽胞菌について深掘りしてみます。
-

増え続ける発達障害と 化学物質 そして腸内細菌の話
近年増加し続けている発達障害。「昔からあった..」というのも1つの真理ではありますが、それとは別の要因として化学物質が関与している可能性も多数報告されています。ここではいくつかの要因について触れていきます。
-

犬の便にはどんな細菌がいる? 解析から見えてきた実情
犬の便にはどんな細菌がいるかご存知ですか?
大腸菌? サルモネラ菌? それとも?
ここでは、腸内細菌の解析データから見えてきた、最新の実情をお届けします。
-

犬と猫の胆泥症、その時腸内で何が?
健康診断で偶発的に見つかることが多い犬と猫の胆泥症(たんでいしょう)。原因不明のことが多い一方で、腸内細菌には顕著な特徴が見られます。いったい何が起きているのでしょうか? 腸内細菌解析から見えてきた多数の実例を元に背景を深掘りします。
-

人喰いバクテリアの話
感染者数が急増し、メディアでも報道されている「人食いバクテリア」。恐ろしそうな名前ですが、一体どんな病原体なのでしょうか?
-

ピロリ菌と仲間たちの話
ピロリ菌は、人間の胃袋だけに感染するものというのが通説です。
ところが、日々多数の腸内細菌を解析していると、犬や猫の腸内からもごくまれに微量の検出があります。これは犬や猫の胃にピロリ菌が存在している可能性を示唆しています。
-

柿と乳酸菌 , そして腸内細菌
晩秋の柿の木には、毎夜のようにツキノワグマがやってきます。Forema と同じ集落内にある柿の木畑でツキノワグマ2頭分のフンを確保し、そこに含まれる微生物 DNAの解析を行ったところ、大量の乳酸菌群が検出されました。
-

猫に乳酸菌はデメリットがあるか?
今も昔も美容や健康にとって重要とされるのが乳酸菌。近年では猫用に乳酸菌入りのフードやサプリが多く販売されています。しかしながら、人間と違って完全肉食性の猫に乳酸菌を与えることでデメリットはないのでしょうか? ここでは腸内細菌研究の視点から、猫の乳酸菌デメリットについて語ります。
-

フェカリス菌って何? 犬と猫の乳酸菌の話
サプリなどでよく耳にするフェカリス菌。なんとなく有名な乳酸菌という認識がある一方で、詳細を知る人は多くないのではないでしょうか?ここでは、フェカリス菌について、犬用/猫用の視点も踏まえてお届けします
-

犬と猫の乳酸菌サプリ まとめ
2,000頭近い犬と猫の腸内細菌を解析してきた知見を元に、犬と猫の乳酸菌サプリ、乳酸菌入りの製品についてご紹介します。
-

犬と猫の「フソバクテリア門」は増やせるか?
腸内細菌の大きな分類の中で、「フソバクテリア門」というグループが存在します。人間では病原性が懸念される一方で、ペットにおいては「増やした方がいい」という誤った認識が広がっているようです。
結論から書くと、「フソバクテリア門を増やしたい」というのはあまり正しい方向ではありません。
-

犬や猫にも効果はあるの? 動物とNMNの話
近年話題の長寿成分NMN(エヌエムエヌ)は、ペットにも効果があるのでしょうか?ここでは、動物とNMN、そして腸内細菌への影響について簡単にご紹介します。
-

歯茎の傷と口腔細菌の話
先日Foremaスタッフが歯科医で歯のクリーニングを行ったところ、手違いで歯茎が傷つき、出血するという事故がありました。(右上/左下の2ヶ所!)
翌日から歯茎が少し腫れ、以後悪化と小康を繰り返しながら、2ヶ月にわたって鈍い痛みが継続することになりました。
この時何が起きていたのでしょうか?
-

腸内細菌から疾患は予測できるか?
腸内細菌が宿主の健康に大きな影響を与えることが詳しく分かってきたのは、21世紀に入りしばらくたってからの事です。
では、腸内細菌を調べれば病気の有無やリスクが分かるのでしょうか?
結論から記載すると、リスクの予測や判定はほぼ可能と言えるでしょう。
ただし1つ1つの疾患を、ピンポイントに判定するという趣旨ではありません。一体どういう事でしょうか?
-

ボツリヌス菌と芽胞菌(がほうきん)
食中毒の原因菌として「ボツリヌス菌」という名前を耳にした事がある人も多いのではないでしょうか?
今回は、何となく身近な、そして恐ろしい存在であるボツリヌス菌と芽胞(がほう)についてのお話です。
-

猫とIBD - ステロイドが効かない時に腸内では何が起きているのか?
人間のみならず、近年では猫においてもIBD(もしくはIBD疑い)の診断が増えています。ここでは腸内細菌解析の現場の視点から、猫のIBD、そしてステロイドが効かなくなる背景について記載します。
-

真相- 犬と猫のビフィズス菌..
過去にも何度か触れたことがある、犬と猫の「ビフィズス菌」。本当に必要なの?それとも..? 最新の知見を元に改めてお届けします。
-

雑巾臭と雑菌の話
梅雨といえば洗濯物の問題があります。そう、生乾きの雑巾臭です。あの匂いは一体どこからやってくるのでしょうか?今回は生乾きの悪臭と細菌についてお届けします。
-

犬と猫の腸内で見られる「らせん菌」ってなんだろう?
動物病院でしばしば耳にする「らせん菌」。ここでは犬と猫の「らせん菌」の素性についてお届けします。
-

犬と猫にも関係する!?薬剤耐性菌の話
お薬が効かない病原性細菌が、世界中で蔓延し始めています。その中でも代表的なのが、「メチシリン耐性 黄色ブドウ球菌(MRSA)」と
「バンコマイシン耐性 腸球菌(VRE)」です。前者の「黄色ブドウ球菌」はアトピー性皮膚炎の悪化に関与する事でも知られています。後者の「腸球菌」とは、いわゆる「フェカリス菌/フェシウム菌」など(エンテロコッカス属)。今回は、前者の「MRSA」についてお届けします。
-

老犬、老猫も要注意。関節の痛み..そして認知症
関節痛の原因の1つとしてリウマチが挙げられます。リウマチは自己免疫疾患の1つで、その根底に炎症の存在があります。そしてそこにいくつかの腸内細菌が関与しています。
-

細菌たちの共謀!? 犬と猫の腸内で起きていること
腸内細菌たちは会話をしています。その方法の一つが「メンブレンベシクル(MV)」と呼ばれるシグナル分子で、ここにはさまざまなメッセージが込められています。
-

植物乳酸菌って何だろう??
しばしば耳にすることも多い「植物乳酸菌」というキーワード。普通の乳酸菌と何が違うのでしょうか??ここでは、植物乳酸菌の概要をザックリと開設します。
-

犬と猫の腸内トラブル~ステロイドの勘違い
炎症系のトラブルで処方されることの多いステロイド。犬や猫でも処方される事は多く、使用したことのある飼い主さんも少なくないはずです。最初のうちは症状が収まるため、不具合が治ったと勘違いしてしまうパターンが多いように見えます。この時何が起きているのでしょうか?
-

乳酸菌はどこからやって来る?
誰もが名前だけは聞いたことがある、身近な存在の乳酸菌たち。これらは、普段どこにいて、どこからやってくるのでしょうか? 発酵食品を例に乳酸菌の背景をご紹介します。
-

犬と猫の腸内トラブルで増える細菌/減る細菌
腸内で異変が起きた時、増えている細菌と減っている細菌が存在します。ただし、増えているから原因、と考えるのは早計かもしれません。
今回はそうした中から1つの事例を(ある程度簡略化して)ご紹介します。
-

犬と猫の腸内細菌,そしてミルクオリゴ糖の話
誰もがご存知であろうオリゴ糖。あまりに日常的に耳にするため、なんとなく平凡なイメージを持つ方も多いかもしれません。 が、オリゴ糖類は、腸内細菌ケアにおいては絶大な威力を発揮します。 今回は、オリゴ糖の中でも有益ながら、あまり注目されることの多くないミルクオリゴ糖(ラクチュロース)について深堀りします。
-

本当に体にいいの? ヨーグルトの真相
各社から多くの種類が販売されているプレーンヨーグルト。その良し悪しはどう判断すればいいのでしょうか? Forema ラボで複数製品の細菌を解析してみました。 結果は... 商品によって、含まれる乳酸菌の種数に大きな開きがありました。
-

偉大な味方か、それとも?? 犬や猫とアッカーマンシア属の話
近年、善玉菌として注目されることの増えた細菌の1つとして、「アッカーマンシア属」をご紹介します。
-

犬や猫からも時々検出..?水底に住む常在細菌の話
Foremaの細菌研究の一環として、金魚の水槽の底にたまった泥状物質を解析しました。様々な細菌たちが検出されましたので、犬や猫に関連しそうな部分をご紹介します。
-

犬と猫にも!?歯周病菌とIBD
当たり前のことですが、口腔と腸内は繋がっています。
従来、口腔細菌は胃酸や胆汁で死滅するので腸内には到達しないと考えられていました。
ところが近年の解析技術の向上により、腸内からも口腔細菌が多く検出される事がわかってきました。
-

盲腸切除で大腸癌リスクが増加?
2022年末、中国の研究チームが行った大規模調査の結果が報告されました。盲腸切除と大腸がんの関連についての興味深い内容なのでご紹介します。
-

犬と猫の大腸炎と皮膚炎、そして腸内細菌
お腹の調子が悪いと、肌の調子も良くない..。多くの人が経験則で知っていることだと思います。当然ながらここにも腸内細菌の関与があり、数多くの論文が存在しています。そんな中から、ここでは大腸炎と皮膚炎(好中球性の皮膚疾患)に関する2022年の論文をご紹介します。
-

食糞(しょくふん)と腸内細菌
愛犬の食糞でお困りの飼い主さんも多いかと思います。食糞の背景については、既存メディアや獣医さんたちによって詳しく説明されている一方、腸内細菌の視点で述べられているものは多くないため、ここで記載します。
-

犬と猫の腸内細菌,そして悪性腫瘍の話
近年の研究から、複数の腸内細菌/口腔内細菌が発癌や進行に関わっている事が少しずつ明らかになっています。 ここでは、今わかっていることの中から、大まかな全体像を俯瞰して記載します。
-

軟便,炎症,涙やけにも関与?犬と猫のレンサ球菌
全身で見られる常在菌の1グループである「ストレプトコッカス属」。一般的には「レンサ球菌」と呼ばれています。多くの感染症や不具合に関与する「レンサ球菌」について、犬と猫の腸内細菌の視点も踏まえて記載します。
-

愛犬,愛猫のアルブミンが低下..その時何が??
蛋白漏出性腸症などに見られるアルブミンの大幅な低下。衰弱し死に至ることも少なくありません。 にもかかわらず、原因不明のままステロイド投与という対処療法に終始することも.. この時腸内で一体何が起きているのでしょうか?いくつかあるパターンの中から、良く見られる1例をご紹介します。
-

犬の分離不安..本当の理由はこれだ!
小型犬を中心に、「分離不安気味」という個体は少なくありません。一体何が原因なのでしょうか? 全てではありませんが、分離不安や行動面に大きな特徴がある個体の多くで、自閉症に関連する腸内細菌が多く検出されています。
-

脾臓は切除しても問題ないか?
人もペットも、医療的な事情から脾臓(ひぞう)の摘出をしなければならない場合があります。
「脾臓は血を溜めておく器官」「なくても生きていける」とはしばしば聞かれる表現ではありますが、必ずしもそうではないかもしれません。
-

私たちが「米ぬか」をおすすめする理由
「米ぬか」とは、お米の外皮や胚芽のこと。精米機によって除去されル部分です。そしてこの部分にこそ重要な成分が含まれています。(多様な食物繊維類、ビタミンB群、マグネシウムや鉄分などのミネラル、そして玄米特有のガンマ オリザノール etc..)
-

病原菌はどこからやって来る?
動物病院の検査で病原性細菌の検出を知らされると、多くの飼い主さんが考えます。
「どこで拾ってきたんだろう?」
「どうやったら減らせる?」
感覚としてはおそらく正常です。ただしこの捉え方は正解ではないかもしれません。
-

誤解多き乳酸菌の話
Foremaでは日々、乳酸菌に関する問い合わせをいただきます。大半の質問が誤解に基づいているため、定期的に情報を発信します。
-

Foremaは お肉屋さんではない,という話
Foremaは、2018年から稼働しているベンチャー企業です(※)。Foremaで購入されている方の多くは、鹿肉や猪肉を購入されているのではないかと思います。
しかしながら、Forema の本当の目的はお肉屋さんではありません。
※法人登記は2017年:前準備は2010年頃から
-

幼犬の原因不明の下痢..。深刻なヘルプサインかも?
10年前には珍しかった、犬や猫のIBD (炎症性腸疾患)。原因不明の下痢が続き、大腸がんなど重篤な疾患のリスクも増加するとされています。
IBDには様々なパターンがありますが、今回は、2~3歳くらいでIBDに苦しむ個体のパターンについて言及します。
-

猫にビフィズス菌サプリが必要でない理由
私たち人間にとってとても重要な存在であるビフィズス菌。犬や猫にとっても重要と考え、サプリメントを探している人も多いのではないでしょうか?
ここでは、愛する猫にとって、ビフィズス菌が本当に必要なのかについて論じます。
-

猫と尿毒素、腎臓..そして腸内細菌の話
猫の健康を考える上で「腎臓」はとても重要な臓器です。特にシニア猫では腎臓の機能が低下しやすく、それに伴って「尿毒素(にょうどくそ)」と呼ばれる有害な物質が体内に溜まりやすくなります。
今回は尿毒素とは何か、増えるとどうなるのかについての一般論、そして腸内細菌との関連について記載します。
-

犬と猫と鹿レバーの話
栄養素の宝庫とも呼ばれるレバー。近年では熱心な飼い主さんを中心に、鹿のレバーに注目が集まっています。レバーにはどんなメリットがあるのでしょうか? また鹿のレバーは一般的なレバーと何が違っているのでしょうか?
-

プロバイオティクスとは何か? 犬と猫の整腸との関係
近年耳にすることの増えた「プロバイオティクス」という言葉。一方で耳慣れず、中身もよくわからないという人も多いはずです。ここでは、特に犬と猫の整腸も踏まえた「プロバイオティクス」について深掘りします。
-

ドッグフードの乳酸菌にメリットはあるか?
飼い主さんの健康志向の高まりで、「乳酸菌入り」をうたったドッグフードが増えています。しかしながら、本当にドッグフードに乳酸菌が必要なのでしょうか? ここでは専門的な内容も踏まえて解説します。
-

生食用のお肉の誤解
「ここのお肉は生食用ですか?」という質問が非常に多いです。しかしながら、国内では「生食用のお肉」というものは存在しません。その背景についてお届けします。
-

猫の「食べない」の深層
愛猫に高いフードや良質のお肉を用意しても、「なぜか食べてくれない」という問題があります。「うちの子は好き嫌いが激しくて..」と思ってしまいがちですが、ここに別の問題が潜んでいる可能性があります。
-

オオカミとグリーントライプの話
乳酸菌や消化酵素が含まれ、獲物を仕留めたオオカミが最初に食べるとされるグリーントライプ。
ところが、アメリカでハイイロオオカミを観察しているミネソタ大学の研究プロジェクトでは、ペット関係者の定説を覆す報告が出ています。
-

猫には猫の乳酸菌(腸球菌)は本当か?
「猫には猫の乳酸菌」というキャッチコピーがあります。この論によれば、猫の主要な乳酸菌は腸球菌(エンテロコッカス属)であり、具体的にはフェカリス菌(E.フェカリス)が重要とされています。本当なのでしょうか?
-

世界最古のワクチン
昨今、改めてワクチンが話題になっています。SNSの一部ではネガティブな情報もしばしば見られます。
ここでは、原点に帰り、「ワクチンのはじまり」に触れてみたいと思います。
-

ドッグフード/キャットフードの数値は本当に重要?
健康や食事を数値で管理しようと取り組む方は少なくありません。重要な取り組みです。一方で、数値に過敏になり、数値に追われているような事例もしばしば見られます。数値が目的になると、本質を見失う可能性があります。
-

愛犬/藍猫の下痢、何を食べれば治る?
Forema には様々な相談ごとが、日々多く寄せられています。大半は消化器トラブル/皮膚トラブルについてです。その中で「何を食べれば良くなりますか?」 という質問はとても多いです。結論から書くと「これを..
-

冬虫夏草は本当に効くのか?
中国で伝統の秘薬として知られる冬虫夏草。癌に効くといったいかがわし噂もあったりなかったり..。でも本当のところはどうなのでしょうか? ここでは代表的な冬虫夏草の1つである「サナギタケ」を中心に記載します。
-

犬と猫にボーンブロスのメリットについて
愛犬や愛猫用にも普及してきたたボーンブロス。Forema でも人気商品の1つです。一方で、そもそもボーンブロスって何? という人も多いのではないでしょうか?
ここでは、愛犬/愛猫にとってのボーンブロスについて、概要やメリットをお届けします。
-

猫のIBD ..ステロイドが効かない時
愛猫に原因不明の下痢や嘔吐が続き、動物病院でIBDと診断されてしまった、そういう事例が増えているようです。ここでは、IBDとは何か? 原因は? そしてステロイドが効かなくなるの? といった内容について記述します。
-

犬の腸内フローラ:健康への影響と研究
犬の腸内フローラは、消化や栄養吸収だけでなく、免疫システムの調節や全身の健康維持に重要な役割を果たしています。腸内に生息する膨大な数の微生物(主に細菌)は、犬の健康状態に大きな影響を与え、腸内フローラのバランスが崩れると、消化器疾患、アレルギー、肥満、行動問題などに繋がることが知られています。ここでは、犬の腸内フローラに関する海外と国内の研究事例をいくつか紹介します。
-

猫の腸内フローラ:健康との関係と最新の研究
猫の腸内フローラは、消化機能、免疫系、そして全身の健康において重要な役割を果たしています。腸内に存在する微生物群は、消化器の健康を維持し、病原菌に対しての防御機能を果たすだけでなく、免疫系の調節にも関与しています。ここでは、猫の腸内フローラに関する国内外の研究事例と文献を紹介し、その重要性と最新の発見について探ります。
-

真菌(しんきん)って何だろう?
真菌(しんきん)をご存知でしょうか?真菌とは、今話題の紅麹をはじめ、麹菌やカビ、酵母、キノコなどのグループです。人間目線だと、カビも細菌も同じに見えますが、大きさは10倍~ほども違い、さらに生物としての構造は全く異なります
-

内臓のメリット- 愛犬/愛猫の栄養補給
「なぜあの飼い主さんは内臓を買っているの? メリットは? そもそもどうやって使うの?」 こんな疑問を持ったことはありませんか? 何となく良さそうだけどよくわからない、そんな内臓について、詳しくご紹介します。
-

犬と猫にも!?タウリンと長寿の話
多くの方が耳にした事であろう成分、タウリン。近年の長寿研究の中で、タウリンにもアンチエイジングの働きがある事がわかってきました。知っているようでよく知らない、タウリンについて深掘りします。
-

腸内フローラの歴史
腸内フローラって何だろう? 腸内フローラとは、人の腸内に生息する多種多様な微生物(細菌、真菌、ウイルスなど)の総体を指します。※英語ではMicrobiome(マイクロバイオーム) これらの微生物は、消化や栄養素の吸収、免疫系の調節など、人体の様々な生理機能に深く関わっています。近年の研究では、腸内フローラのバランスが健康状態や病気の発症に大きく影響を与えることが明らかにされています。
-

食材としての脾臓(ひぞう)の話
脾臓は、食材としては極めてマイナーな部位です。レバーのすぐ脇に位置し、一時的に血を溜めておく役割があります。急に走って脇腹が痛くなるのは、脾臓の収縮によるものとされています。
ここでは、食材としての脾臓についてまとめてみました。手作りご飯の素材の選択肢としてもご活用ください。
-

愛犬にとっての腸内フローラ検査のメリット
愛犬の健康長寿へのニーズが、かつてないほど高まっています。飼い主さんにとっての何よりの関心ごとは愛犬の食と健康状態ではないでしょうか。その健康管理の一環として注目されているのが、「腸内フローラ検査(腸内細菌の解析)」です。この検査は人間のみならず、犬にとっても多くのメリットがあります。ここでは、腸内フローラ検査が愛犬の健康管理にどう役立つのかをご紹介します。
-

犬と猫のケストース,メリットとデメリット
昨今耳にすることの増えたケストース。オリゴ糖の王様というキャッチコピーまで登場し、気になっている人もいるかもしれません。
ここではケストースについての概要と、犬や猫にとっての扱いについて解説します。
-

犬の総合栄養食、その成分と役割について
-

犬のIBD.. ステロイドが効かない時に起きている事
近年増加している犬のIBD (炎症性腸疾患)。最初は効果の出ていたステロイドが、やがて効かなくなるケースが少なくありません。この時腸内で、何が起きているのでしょうか? 腸内細菌の視点から記述します。
-

猪肉ドッグフード「Forema Basis 猪」販売開始
国産野生種の猪肉を主原料としたドッグフード(総合栄養食)「Forema Basis 猪」が販売開始となりました。以下、製品の特徴とメリットをご紹介します。
-

犬と猫に、オリゴ糖のリスクとメリット
整腸サプリや健康食品で定番のオリゴ糖。良く耳にするけれど、リスクはないのでしょうか?
ここでは、犬と猫にとって、オリゴ糖のリスク、そしてメリットを腸内細菌ケアの観点から記載します。
-

犬の乳酸菌サプリ/乳酸菌製品
Forema から販売している犬の乳酸菌製品および、乳酸菌を使用した商品についてご紹介します。
-

猫にボーンブロスを飲ませてもいいの?
近年、ペットの間でもボーンブロスが注目されはじめています。特に鹿のボーンブロスは流通が少ない一方で、自然食という背景もあって静かな人気を呼んでいます。
ここでは、愛猫にとっての鹿のボーンブロスの可否、メリットなどをお届けします。
-

猫にとってイヌリンとオリゴ糖は役に立つか?
人間の整腸において定番となったオリゴ糖やイヌリン。猫にとっては有益なのでしょうか? そもそも猫に与えて大丈夫なものなのでしょうか?ここでは、実際に自社ラボで腸内細菌を解析して得られた実例やデータをもとに、猫のイヌリンとオリゴ糖について記載します。
-

ウサギの腸内細菌解析 ベータ版 開始
ペットとして、静かながらも高い人気を誇るウサギさん用に、腸内細菌解析「byOm-Rabbit(バイオーム ラビット)」をリリースしました。
当面はベータ版としてリーズナブルな価格帯で提供していきます。
-

猫の食事と鹿肉のメリットについて
猫は私たちの大切な家族。猫の食事はその生活の質と直接的に関連しており、栄養バランスが取れた食事は、猫の幸せと長寿に欠かせません。ここでは、特に鹿肉に絞って、猫にとってのメリットを記載します。
-

鹿肉ドッグフード Forema Basis リニューアルのお知らせ
鹿肉と歯科の内臓をふんだんに使用した犬用総合栄養食「Forema Basis(フォレマ ベーシス)」が、2023年5月製造分よりリニューアルしました。
>> 鹿肉ドッグフード Forema Basis
-

犬の下痢/猫の下痢はオリゴ糖で治せるか
犬や猫の下痢でお困りの飼い主さんから相談を受ける事例が増えています。ここではオリゴ糖にテーマを絞り、愛犬/愛猫の下痢が解決できるかについて考察します。
-

鹿肉と乳酸菌/プレバイオティクスのキャットフード 販売開始
鹿肉を主原料とした総合栄養食「Forema Basis(フォレマ ベーシス)」に猫用が登場しました。
-

ボーンブロスと腸内環境の話
近年ダイエットの文脈で話題となることの多いボーンブロス(骨のスープ)。 実は、犬や猫の腸内環境にとっても有益なアイテムです。ここでは、ボーンブロスの知られざる底力についてお届けします。
-

抗酸化物質 グルタチオンについて
一般的には耳にする事がない一方、抗老化にとって有効な成分と考えられているグルタチオンについて、大まかな概要を記載します。
-

食欲増進用のプレバイオティクス 「大地のふりかけ」販売開始
好き嫌いの激しい個体や、歳をとって食欲が落ちてきたシニアのために、体と腸内細菌に優しい「大地のふりかけ 乳酸菌ミックス」が登場しました。乳酸菌発酵(細菌類)と、麹菌発酵(新菌類)の2つの発酵によって生まれた、人や動物が好む豊かな発酵臭が詰まっています。
-

犬と猫のオリゴ糖セット 販売開始しました
腸内ケアに有益なオリゴ糖の中から、特に有益な2種類をお届けするオリゴ糖セットの販売を開始しました。
-

犬用の総合栄養食 Forema Basis 鹿 発売
ご要望の多かった犬用の総合栄養食、Forema Basis 鹿(フォレマベーシス) の販売を開始しました。
Forema Basis の特徴は、鹿肉と鹿の内臓5種類をたっぷり使用している点。特にお肉の含有量は、フード形成が可能なギリギリまで高めています。
-

鹿のボーンブロスも登場しました
猪のボーンブロスに引き続き、鹿のボーンブロスが登場しました。 国産野生種の鹿の骨を、ただグツグツ煮込んだだけの、何も足さない天然のスープ。350ccと500ccの2サイズでお届けします。
-

猪のボーンブロス 濃厚バージョンが登場しました
老犬の栄養補給や腸内ケアにも活躍する、猪のボーンブロス(骨のスープ)に「濃厚バージョン」が登場しました。
濃厚バージョンは少量しか製造できないため、在庫があった際には前向きにご検討ください。
-

よく分かる! 犬と猫の酪酸菌のお話
健康志向の高い人たちから注目されている「酪酸菌(らくさんきん)」。近年では愛犬用/愛猫用に酪酸菌サプリの需要が増えてきたため、「犬と猫の酪酸菌」についてまとめてみたいと思います。